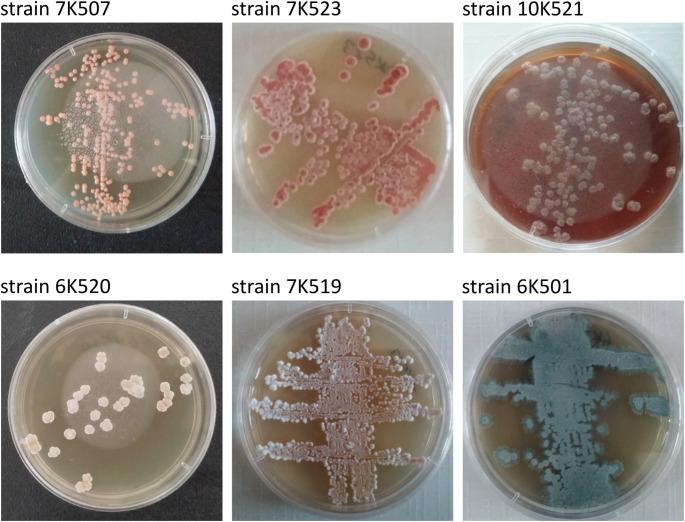
https://cdn.ncbi.nlm.nih.gov/pmc/blobs/6740/12187853/68afc0142e26/11274_2025_4399_Fig5_HTML.jpg

卡拉库姆沙漠:一个具有独特生物合成潜力的可培养新型稀有放线菌的独特来源。
Karakum desert: a unique source of cultivable novel and rare actinomycetes with a remarkable biosynthetic potential.
作者信息
Saygin Hayrettin, Sahin Nevzat, Goodfellow Michael
机构信息
Department of Molecular Biology and Genetics, Faculty of Sciences, Ondokuz Mayis University, Samsun, 55139, Turkey.
School of Natural and Environmental Sciences, Newcastle University, Ridley Building 2, Newcastle upon Tyne, NE1 7RU, UK.
出版信息
World J Microbiol Biotechnol. 2025 Jun 24;41(7):202. doi: 10.1007/s11274-025-04399-3.
A culture-based strategy was used to isolate and screen representative actinomycetes from six sampling sites in the Karakum Desert, Turkmenistan. A total of 459 actinomycete isolates were obtained using 16 selective media, and 270 representative strains were subjected to 16 S rRNA gene sequencing. Comparative 16 S rRNA gene sequence analyses on colour-group representatives led to their assignment to 17 genera with validly published names which included many isolates assigned to novel or putatively novel species including ones belonging to rare genera, such as Actinocorallia, Actinomadura, Jiangella and Nonomuraea. Mining of whole-genome sequences of 32 isolates which formed distinct lineages in phylogenomic trees revealed biosynthetic gene clusters predicted to encode for many novel specialized metabolites, notably antibiotics. The genomes of most of these isolates included genes associated with the promotion of plant growth while bioinformatic analyses of stress-related genes provided on insight into how filamentous actinomycetes have adapted to harsh environmental conditions in the Karakum Desert. This extensive bioprospecting campaign shows that the Karakum Desert is a unique source of novel, rare and gifted filamentous actinomycetes with the ability to synthesise new specialized metabolites needed to address key existential issues facing humankind, especially, the urgent need to find a new generation of therapeutic antibiotics to control multidrug-resistant microbial pathogens and compounds that protect and promote plant growth.
采用基于培养的策略,从土库曼斯坦卡拉库姆沙漠的六个采样点分离和筛选代表性放线菌。使用16种选择性培养基共获得459株放线菌分离株,并对270株代表性菌株进行16S rRNA基因测序。对颜色组代表进行的16S rRNA基因序列比较分析,使其被归入17个有效发表名称的属,其中包括许多被归入新物种或假定新物种的分离株,包括属于稀有属的分离株,如珊瑚放线菌属、马杜拉放线菌属、姜氏菌属和野野村氏菌属。对在系统发育树中形成不同谱系的32株分离株的全基因组序列进行挖掘,发现了预测可编码许多新型特殊代谢产物(尤其是抗生素)的生物合成基因簇。这些分离株中的大多数基因组都包含与促进植物生长相关的基因,而对与应激相关基因的生物信息学分析提供了对丝状放线菌如何适应卡拉库姆沙漠恶劣环境条件的洞察。这项广泛的生物勘探活动表明,卡拉库姆沙漠是新型、稀有且有天赋的丝状放线菌的独特来源,这些放线菌能够合成解决人类面临的关键生存问题所需的新特殊代谢产物,特别是迫切需要找到新一代治疗性抗生素来控制多重耐药微生物病原体以及保护和促进植物生长的化合物。